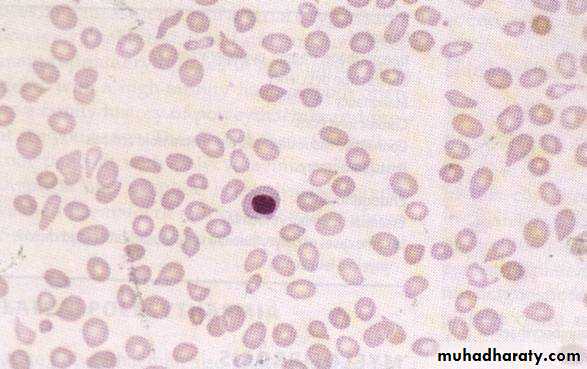

Polycythaemia vera
• Definition of polycythemia• Raised packed cell volume (PCV / HCT)
• Male > 0.52 (52%)
• Female > 0.48 (48%)
• Classification
• Absolute ;if male with HCT ≥0.60,female≥0.56
• Primary proliferative polycythaemia (polycythaemia vera)
• Secondary polycythaemia
• Idiopathic erythrocytosis
• Apparent
• Plasma volume or red cell mass changes
• The presence of hypertension, smoking, excess alcohol consumption and/or diuretic use is consistent with low volume polycythaemia (Gaisbock’s syndrome)
• Clinical features
• Age > 40 year• May occur in young adults and rare in childhood
• symptoms of hyperviscosity, such as lassitude, loss of concentration, headaches, dizziness, blackouts, pruritus and epistaxis
• Majority patients present due to vascular complications
• Thrombosis (including portal and splenic vein)
• DVT
• Hypertension
• poor vision
• Skin complications ( aquagenic pruritus, erythromelalgia)
• Haemorrhage (GIT) due to platelet defect
• Hepatosplenomegaly
• Erythromelalgia
• Increased skin temp
• Burning sensation
• Redness
Erythromelalgia
→40%
70%
Investigation
* mutation in a kinase, JAK-2 V617F, is found in over 90% of cases .If JAK-2 mutation is negative , measurement of red cell mass.
• Laboratory features and morphology
• Hb, PCV (HCT), and Red cell mass increased
• Increased neutrophils and platelets
• Plasma urate high
• Hypercellular bone marrow
• Low serum erythropoietin
TREATMENT
*Aspirin reduces the risk of thrombosis.* Venesection gives prompt relief of hyperviscosity symptoms. Between 400 and 500 mL of blood (less if the patient is elderly) are removed and the venesection is repeated every 5–7 days until the haematocrit is reduced to below 45%.
*Suppression of marrow proliferation with hydroxycarbamide or interferon alfa may reduce the risk of vascular occlusion, control spleen size and reduce transformation to myelofibrosis
Secondary polycythaemia
• Polycythaemia due to known causes
• Compensatory increased in EPO
• High altitude
• Pulmonary diseases
• Heart dzs eg- cyanotic heart disease
• Abnormal hemoglobin- High affinity Hb
• Heavy cigarette smoker
• Inappropriate EPO production
• Renal disease-carcinoma, hydronephrosis
• Tumors-fibromyoma and liver carcinoma
• Investigation
• Arterial blood gas
• Hb electrophoresis
• Oxygen dissociation curve
• EPO level
• Ultrasound abdomen
• Chest X ray
• Total red cell volume(51Cr)
• Total plasma volume(125 I-albumin)
MyelofibrosisChronic idiopathic myelofibrosis
• Progressive fibrosis of the marrow & increase connective tissue element
• Agnogenic myeloid metaplasia
• Extramedullary erythropoiesis
• Spleen
• Liver
• Abnormal megakaryocytes
• Platelet derived growth factor (PDGF)
• Platelet factor 4 (PF-4)
Myelofibrosis-Cont.
• Insidious onset in older people• Splenomegaly- massive
• Hypermetabolic symptoms
• Loss of weight, fever and night sweats
• Bone pain
• Gout
• Anaemia
• High WBC at presentation
• Later leucopenia and thrombocytopenia
• Leucoerythroblastic blood film
• Tear drops red cells
• Bone marrow aspiration- Failed due to fibrosis
• Trephine biopsy- fibrotic hypercellular marrow
• The presence of a JAK-2 mutation supports the
• diagnosis.
Myelofibrosis-Treatment
Red cell transfusions for anaemia.Folic acid should be given to prevent deficiency.
Cytotoxic therapy with hydroxycarbamide may help control spleen size, the white cell count or systemic symptoms.
Splenectomy may be required for a grossly enlarged spleen or symptomatic pancytopenia secondary to splenic pooling of cells and hypersplenism.
HSCT may be considered for younger patients.
Ruxolitinib, an inhibitor of JAK-2.
Essential thrombocythaemia(ET)Primary thrombocytosis / idiopathic thrombocytosis
• Clonal myeloproliferative disease of megakaryocytic lineage• Sustained thrombocytosis
• Increase megakaryocytes
• Thrombotic or/and haemorrhage episodes
• Positive criteria
• Platelet count >600 x 109/L
• Bone marrow biopsy; large and increased megas.
• The presence of a JAK-2 mutation supports the diagnosis but is not universal.
• Criteria of exclusion
• No evidence of Polycythaemia vera
• No evidence of CML
• No evidence of myelofibrosis (CIMF)
• No evidence of myelodysplastic syndrome
• No evidence of reactive thrombocytosis
• Bleeding
• Trauma
• Post operation
• Chronic iron def
• Malignancy
• Chronic infection
• Connective tissue disorders
• Post splenectomy
Essential thrombocythaemia(ET)
• Clinical features
• Haemorrhage
• Microvascular occlusion
• TIA, gangrene
• Splenic or hepatic vein thrombosis
• Hepatosplenomegaly
Treatment
* Low dose aspirin to reduce the risk of occlusive vascular events.
* Low risk patients (age < 40 years, platelet count < 1000 × 109/L and no bleeding or thrombosis) may not require treatment to reduce the platelet count.
* For those with a platelet count above 1000 × 109/L, with symptoms, or with other risk factors for thrombosis such as diabetes or hypertension, treatment to control platelet counts should be given.
** Agents include oral hydroxycarbamide or anagrelide, an inhibitor of megakaryocyte maturation.
Intravenous radioactive phosphorus (32P) may be useful in old age.